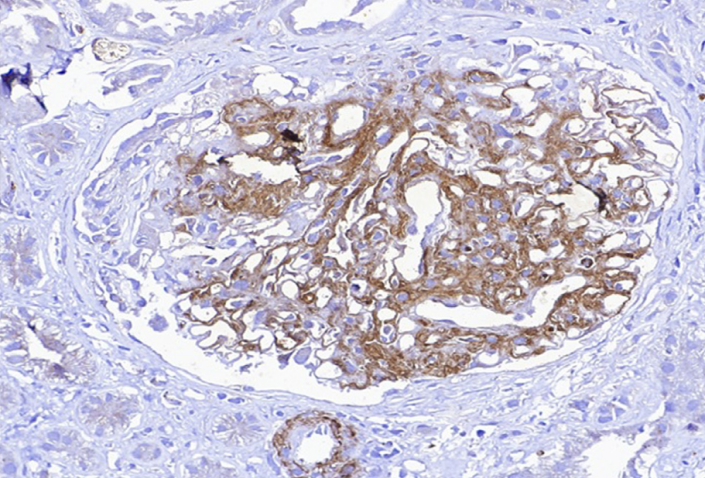

发表时间:2026-02-03 10:13:29
系统性红斑狼疮(systemic lupus erythematosus,SLE)是一种慢性炎症性自身免疫疾病,可累及多个器官系统,其中狼疮性肾炎是导致SLE患者死亡率和致残率升高的重要因素。及时诊断和早期治疗对于改善患者预后至关重要。然而,部分患者可能表现为非典型的肾脏受累。本研究报告了两例SLE患者的罕见肾脏病理学表现,提示临床医生在处理复杂病例时需高度重视肾活检的重要价值。
病例一:患者为50岁女性,既往有糖尿病及高血压病史2年。因全身水肿15天就诊。常规检查提示贫血(血红蛋白10.8 g/dL)、血小板减少(54 000/μL),血清肌酐明显升高至5.5 mg/dL。尿液检查仅见轻度蛋白尿(10 mg/dL)。腹部超声提示双肾大小正常,但肾实质回声增强。自身免疫学检查示抗核抗体(ANA)及抗双链DNA(抗 dsDNA)抗体均呈阳性。值得注意的是,血清游离κ轻链检测强阳性,血清κ/λ游离轻链(FLC)比值>100。
病例一:肾组织活检显示肾小管、血管及肾小球毛细血管壁存在κ轻链线样沉积。该表现符合κ轻链单克隆免疫球蛋白沉积病,病变主要累及肾小管间质,并伴局灶性急性肾小管损伤(图1、图2)。

图1. PAS染色(40倍)显示系膜基质和细胞数量轻度增加

图2. 免疫荧光显示,在蛋白质重吸收颗粒以及血管壁的沉积物中,κ(Kappa)呈阳性

图4. 电子显微镜显微照片显示基底膜内有纤维状沉积
三、讨论
这两例患者均为SLE合并非典型肾脏病变:
MGRS与FGN虽罕见,但应纳入SLE合并肾损害的鉴别诊断范围。
准确的病理学分型对于制定个体化治疗方案至关重要。
这类患者通常预后较差,需多学科团队合作,结合免疫抑制、靶向及支持治疗综合管理。
未来仍需更多病例研究和长期随访,以深入阐明SLE合并罕见肾脏病理类型的发病机制和最佳治疗策略。
来源:Nasar, Ariba et al. WCN25-1130 UNMASKING THE UNUSUAL: KIDNEY BIOPSY IN SYSTEMIC LUPUS ERYTHEMATOSUS. Kidney International Reports, Volume 10, Issue 2, S191 - S192.